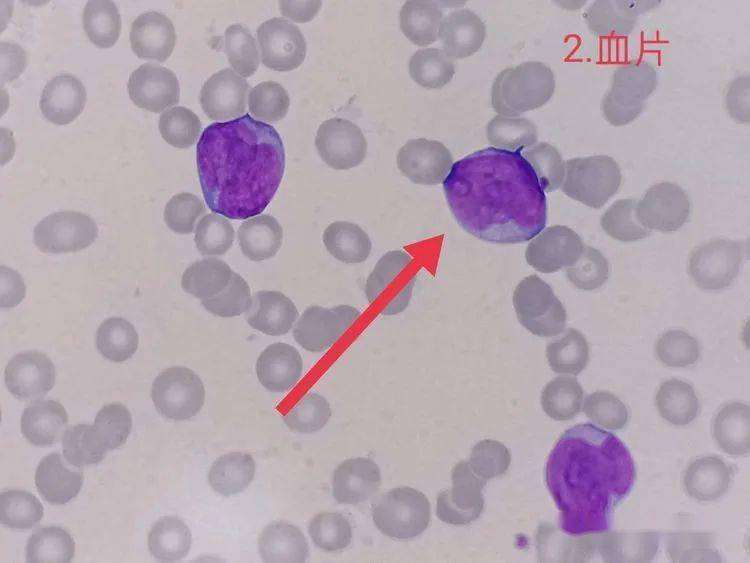
胞体内含一巨大包涵体结构,呈紫红色颗粒样,可能为吞噬的细胞核退化

退化细胞

退化的细胞核/涂抹细胞 38
图片尺寸650x484
退化的上皮细胞,你见过吗
图片尺寸3968x1984
退化的上皮细胞,你见过吗
图片尺寸3968x1984
退化的上皮细胞,你见过吗
图片尺寸3968x1984
退化的上皮细胞,你见过吗
图片尺寸3968x1984
细胞凋亡,退化,有聚集
图片尺寸911x1620
退化的细胞嗜碱性粒细胞中性:一会儿我们一起看看如何清晰划分晚期粒
图片尺寸960x727
胞体内含一巨大包涵体结构,呈紫红色颗粒样,可能为吞噬的细胞核退化
图片尺寸750x563
「狼疮细胞」 狼疮细胞为中性粒细胞吞噬了退化的均匀体,多见于
图片尺寸650x561
外周血涂片#淋巴细胞白血病
图片尺寸644x1082
生物化学 诺贝尔奖 机制 细胞学 退化 插图 细胞 饮食照片
图片尺寸450x300
退化变性的柱状细胞与腺癌细胞示意图
图片尺寸551x159
糖尿病患者积液的间皮细胞往往都是退化的间皮比较多(肝硬化,动脉粥样
图片尺寸1080x764
「(退化)mott细胞」形态特征:胞体巨大,呈不规则形;胞核小,不规则,有
图片尺寸1040x770
凋亡粒细胞5. 退化的间皮细胞(胸水标本)4.细胞溶解3.小细胞癌细胞2.
图片尺寸1104x828
退化变性的柱状细胞与腺癌细胞示意图
图片尺寸571x168
英国研究人员确认了人体的一些器官的衰老退化时间:1,肺活量:20岁起
图片尺寸640x417
手指或脚趾的发育及青蛙尾巴的退化都是细胞凋亡的结果
图片尺寸361x480
手指或脚趾的发育及青蛙尾巴的退化都是细胞凋亡的结果
图片尺寸1280x640
求助 这是髓核细胞嘛
图片尺寸640x853